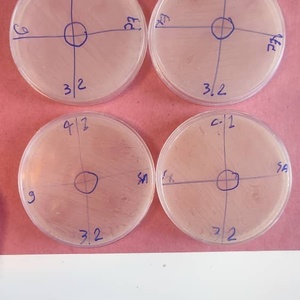
تصویر گالری

سعید فرخزاد
تهران
0 نظر0
جدول قیمتنظرهااطلاعات متخصصگالری تصاویر
درباره من
من دارای مدرک دکترای تخصصی ودارای بیش از ده سال کار تخصصی در حوزه نگارش پروپوزال و پایان نامه هستم. تمامی کارهای من ۱۰۰% تضمینی هستند و تاکید میکنم برای تمامی کارها گواهی کپی سنجی یا همانندجویی ارسال خواهد شد وتضمین میکنم تمامی کارهای من جدید و با همانندجویی زیر 20% است.
تخصص های سعید فرخزاد
گالری تصاویر